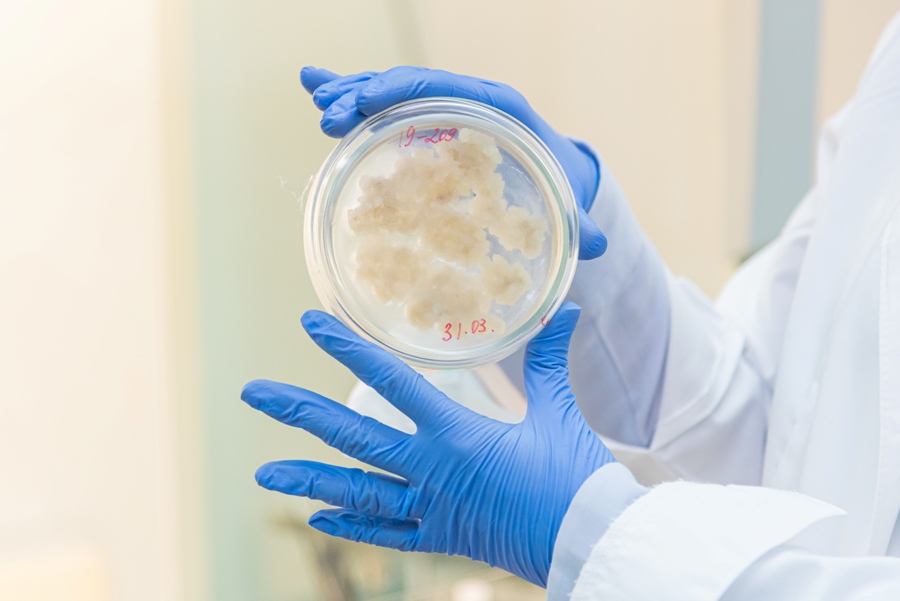

На кафедры біяхіміі ўдалося стварыць магутны інавацыйны навуковы цэнтр, які дзякуючы поспехам у галіне фундаментальных даследаванняў аказвае навукаёмістыя паслугі, тым самым прыцягваючы ва ўніверсітэт пазабюджэтныя сродкі. Тут навукоўцы займаюцца лекавай бяспекай Беларусі ў акрэдытаваная лабараторыя біяхіміі і фармакалогіі біялагічна актыўных рэчываў. Таксама вывучаюць унікальны шматфункцыянальны бялок груднога малака лактаферын. А яшчэ займаюцца метабалічнай інжынерыяй суспензійных культур клетак. Падрабязнасці распавёў загадчык кафедры.
Метабаломіка і фармацэўтычная біятэхналогія
Сярод асноўных напрамкаў фундаментальных даследаванняў кафедры біяхіміі біялагічнага факультэта БДУ варта вылучыць метабаломіку, якая адносіцца да так званых постгеномных тэхналогій. Прадметам вывучэння метабаломікі з’яўляецца метабалом – сукупнасць усіх нізкамалекулярных метабалітаў арганізма.
Метабалом па сваёй фундаментальнай значнасці не саступае геному (сукупнасці ўсіх генаў) ці пратэому (сукупнасці ўсіх бялкоў) і ўяўляе сабой своеасаблівую “хімічную праекцыю” геному, якая рэалізуецца праз пратэом.
Загадчык каферды Ігар СЯМАК сцвярджае:
– У наш час дзякуючы развіццю метабаломікі здзейснены якасны прарыў у разуменні клетачных і малекулярных асноў жыццядзейнасці жывых аб’ектаў, што дазволіла дасягнуць значных поспехаў у біятэхналогіі, медыцыне і сельскай гаспадарцы. Напрыклад, лічыцца, што даследаванні ў галіне метабаломікі акажуць на медыцыну больш істотны ўплыў, чым праект “Геном чалавека”, бо метабалом значна больш дакладна адлюстроўвае фізіялагічныя і патафізіялагічныя працэсы, якія праходзяць у арганізме, што дазваляе выкарыстоўваць яго не толькі для ранняй дыягностыкі захворванняў чалавека, але і для ацэнкі схільнасці да паталогіі. Метабалічнае тэсціраванне з’яўляецца надзейным спосабам ацэнкі здароўя чалавека на працягу ўсяго яго жыцця. У выпадку спартыўнай медыцыны аналіз метабалому чалавека дапамагае абраць дыету і рэжым трэніровак, якія адпавядаюць яго індывідуальнаму абмену рэчываў.
На кафедры біяхіміі распрацоўваюцца навукова-метадычныя асновы метабаломнага прафілявання біялагічных вадкасцяў для аптымізацыі існуючых і стварэння новых алгарытмаў клініка-лабараторнай дыягностыкі паталогій сардэчна-сасудзістай і нервовай сістэм, захворванняў скуры.
Супрацоўнікамі кафедры біяхіміі кафедры біяхіміі ў рамках сумесных праектаў з навуковымі ЗША (універсітэт Тэнесі) былі адкрыты новыя шляхі метабалізму цэлага шэрагу біялагічна актыўных рэчываў жывёльнага і расліннага паходжання: мелатаніну (нейрагармон) і сератаніну, стэроідаў (эргастэролу, вітаміну Д2, а таксама вітаміну Д3 і яго папярэдніка 7-дэгідрахалестэролу), флаваноідаў. Працы носяць прыярытэтны характар, атрымалі міжнароднае прызнанне і апублікаваны ў 30 прэстыжных навуковых выданнях, у тым ліку ў часопісе з імпакт-фактарам 15 (Journal of Pineal Research).
– Метабаломныя даследаванні дазваляюць адрозніць “нармальны” метабалізм ад “змененага”, і таму паспяхова прымяняюцца ў ЗША, Японіі і краінах Еўрапейскага саюза пры распрацоўцы новых лекавых сродкаў і метадаў малекулярнай дыягностыкі. Метабалічныя маркеры, якія ўтвараюцца ў арганізме чалавека ў адказ на дзеянне лекаў, могуць выкарыстоўвацца для ацэнкі іх таксічнасці, а таксама для выяўлення людзей, што “нестандартна” рэагуюць на той ці іншы лекавы прэпарат. Вызначэнне канцэнтрацыі лекавага рэчыва і яго метабалітаў з’яўляецца ключавым момантам пры правядзенні тэрапеўтычнага лекавага маніторынгу. У сувязі з гэтым відавочна, што метабаломіка істотна паскарае працэс стварэння новых лекаў і значна павялічвае шанцы на бяспечнае і эфектыўнае іх прымяненне, — працягвае загадчык кафедры.
Акрэдытаваная лабараторыя біяхіміі і фармакалогіі біялагічна актыўных рэчываў
Навукова-метадычныя распрацоўкі па метабаломіцы дазволілі кафедры перайсці да рашэння шэрагу актуальных прыкладных праблем, звязаных з лекавай бяспекай Беларусі. На кафедры функцыянуе акрэдытаваная лабараторыя біяхіміі і фармакалогіі біялагічна актыўных рэчываў, якая сёння з’яўляецца адным з вядучых цэнтраў у СНД па правядзенні аналітычных этапаў біяэквівалентных выпрабаванняў джэнерыкаў – лекаў, якія з’яўляюцца копіямі арыгінальных прэпаратаў.

Мас-спектрометр
– Перш чым патрапіць у аптэкі, джэнерыкі (узноўленыя прэпараты) павінны прайсці жорсткія выпрабаванні, якія даказваюць іх фармацэўтычную, біялагічную і тэрапеўтычную эквівалентнасць з арыгіналам, – тлумачыць ігар Віктаравіч. – Навукоўцы кафедры распрацоўваюць унікальныя аналітычныя методыкі, якія дазваляюць дакладна вызначаць змест лекавага рэчыва ў крыві добраахвотнікаў, што прымалі арыгінальны і ўзноўлены прэпараты. Атрыманыя вынікі выкарыстоўваюцца для пабудовы фармакакінетычных крывых, а затым для параўнальнай ацэнкі такіх важных фармакакінетычных паказчыкаў, як максімальная канцэнтрацыя ў крыві лекавага злучэння, хуткасць яго ўсмоктвання, размеркавання і вывядзення з арганізма.
Ужо праведзена больш за 130 выпрабаванняў для айчынных і замежных фармацэўтычных прадпрыемстваў з Расіі, Украіны, Польшчы і інш. Высокі ўзровень даследаванняў дазваляе кафедры біяхіміі на рэгулярнай аснове прыцягваць пазабюджэтныя сродкі ў рамках міжнародных кантрактаў і гаспадарчых дамоў. Дзякуючы гэтаму кафедра палепшыла сваю матэрыяльна-тэхнічную базу.
Метабалічнай інжынерыі суспензійных культур клетак
Напрацоўкі ў галіне метабаломікі сталі штуршком для развіцця на кафедры яшчэ аднаго прыкладнога напрамку: метабалічнай інжынерыі лекавых раслін. Гэта даследаванне спецыфічных асаблівасцяў метабалізму ў розных арганізмаў, канструяванне новых арганізмаў і сістэм з накіравана змененымі метабалічнымі ператварэннямі субстратаў у прадукты жыццядзейнасці для іх выкарыстання ў прамысловасці, медыцыне, ветэрынарыі і экалогіі.

На кафедры вядуцца працы па метабалічнай інжынерыі суспензійных культур клетак з калуснай тканкі цісу з мэтай стварэння прадуцэнтаў таксанаў – алкалоідаў цісавага дрэва. Сёння прэпараты, якія змяшчаюць у якасці актыўных рэчываў такія таксаны, як паклітаксел і дацэтаксел, займаюць адну з ключавых пазіцый у клінічнай хіміятэрапіі шэрагу пухлінных захворванняў (рак малочнай залозы, рак яечнікаў, рак лёгкага). Ігар Віктаравіч кажа:
– Чаму дадзены напрамак уяўляе для нас такую цікавасць? Экстракцыя таксанаў з кары ці іголак цісу патрабуе даволі складаных сістэм і дарагіх тэхналогій, з прычыны чаго з’яўляецца ў цэлым маларэнтабельнай. Для напрацоўкі 1 кг прэпарата паклітакселу неабходна 14,5 т сухой кары, атрыманай ад 1000 дрэў 100-гадовага ўзросту, а для экстракцыі колькасцяў, якія выкарыстоўваюцца для лячэння аднаго пацыента (2,5-3,0 г паклітакселу), патрабуецца каля васьмі 60-гадовых дрэў.
Альтэрнатыўнай крыніцай таксанаў з’яўляюцца клетачныя культуры раслін. Выкарыстанне клетачных культур цісу мае шэраг пераваг: незалежнасць ад прыроднай сыравіны і сезонных ваганняў зместу алкалоідаў у сыравіне, памяншэнне сабекошту фармсубстанцый, захаванне цяжкааднаўляльных біярэсурсаў. У наш час найбуйнейшымі вытворцамі паклітакселу з культур клетак з’яўляюцца кампаніі Python Biotech, Corean Samyang Genex Corporation. Кампанія Samyang Genex Corporation вырабляе каля 20 кг паклітакселу пад гандлёвай маркай Genexol® у год. Аб’ём сусветнага рынку паклітакселу і яго паўсінтэтычных аналагаў складае 5,4 млрд долараў ЗША ў год. Цяпер айчынныя вытворцы лекавых прэпаратаў закупляюць дарагую субстанцыю паклітакселу за мяжой, у сувязі з чым актуальнасць развіцця напрамку на кафедры відавочная.
Лактаферын – унікальны шматфункцыянальны бялок груднога малака
Яшчэ адзін інавацыйны напрамак звязаны з распрацоўкай высокаэфектыўных і біялагічна бяспечных лекавых сродкаў новага пакалення, атрыманых з дапамогай генна-інжынерных тэхналогій. Кафедра біяхіміі сумесна з навукоўцамі НАН Беларусі прымала актыўны ўдзел у выкананні праграмы саюзнай дзяржавы « БелРасТрансген-2».

На кафедры біяхіміі была распрацавана тэхналогія вылучэння рэкамбінантнага лактаферыну чалавека з малака трансгенных коз-прадуцэнтаў, выведзеных у РУП “НВЦ НАН Беларусі па жывёлагадоўлі”. З дапамогай сучасных фізіка-хімічных метадаў аналізу спецыялістамі кафедры была ўсталявана ідэнтычнасць рэкамбінантнага чалавечага лактаферыну і прыроднага лактаферыну з жаночага малака. Вынікі даследаванняў былі апублікаваны ў вядучым міжнародным часопісе ў галіне стварэння і вывучэнняі трансгенных арганізмаў – Transgenic Research. Лактаферын – гэта ўнікальны шматфункцыянальны бялок груднога малака, які забяспечвае злучэнне і транспарт іонаў жалеза, валодае супрацьвірусным і антыбактэрыяльным дзеяннем, дзякуючы чаму абараняе нованароджанага ад патагенных мікраарганізмаў датуль, пакуль не запрацуе яго ўласны імунітэт.
Разнастайнасць функцыянальных уласцівасцяў лактаферыну тлумачыць павышаны попыт на яго як субстанцыю для вытворчасці лекавых прэпаратаў, прадуктаў функцыянальнага харчавання і біялагічна актыўных дадаткаў да ежы рознанакіраванага дзеяння. З усяго жывёльнага лактаферыну, які вырабляецца ў свеце, 75 % закупляе Японія, 12% – Паўднёвая Карэя, дзе яго дадаюць у дзіцячае харчаванне як харчовы дадатак. Харчовыя дадаткі з лактаферынам афіцыйна ўжываюць спартсмены ЗША і Аўстраліі.
У наш час на кафедры выконваецца сумесны праект з навукоўцамі Ляанінскага ўніверсітэта (Кітай) па атрыманні біялагічна актыўных комплексаў лактаферын-поліцукрыд, здольных прадухіляць паражэнне β-клетак падстраўнікавай залозы пры дыябеце.
Інавацыйны навуковы цэнтр
– Навукова-метадычная і матэрыяльная база, сфарміраваная ў выніку выканання інавацыйных праектаў, дазволіла стварыць на кафедры біяхіміі Навучальны навукова-вытворчы ўчастак па вопытнай вытворчасці біяфармацэўтычных прэпаратаў. Участак выкарыстоўваецца ў якасці практычнай базы для падрыхтоўкі высокакваліфікаваных кадраў для новага сегмента нацыянальнай эканомікі – высокатэхналагічнай навукаёмістай біяфармацэўтычнай вытворчасці, а таксама з’яўляецца ўнікальнай з’явай не толькі для Рэспублікі Беларусь, але і для іншых краін СНД. Можна з упэўненасцю сцвярджаць, што на дадзены момант кафедра біяхіміі з’яўляецца адзіным навучальным цэнтрам у Рэспубліцы Беларусь, які ажыццяўляе падрыхтоўку спецыялістаў у галіне фармацэўтычнай біятэхналогіі, – распавядае Ігар Сямак.
Такім чынам, на кафедры біяхіміі ўдалося стварыць магутны інавацыйны навуковы цэнтр, які дзякуючы поспехам у галіне фундаментальных даследаванняў здольны аказваць навукаёмістыя паслугі, тым самым прыцягваючы ва ўніверсітэт пазабюджэтныя сродкі і павышаючы сваю незалежнасць ад дзяржаўных рэсурсаў.
Гутарыла Алена ЛЯЎШЭНЯ
